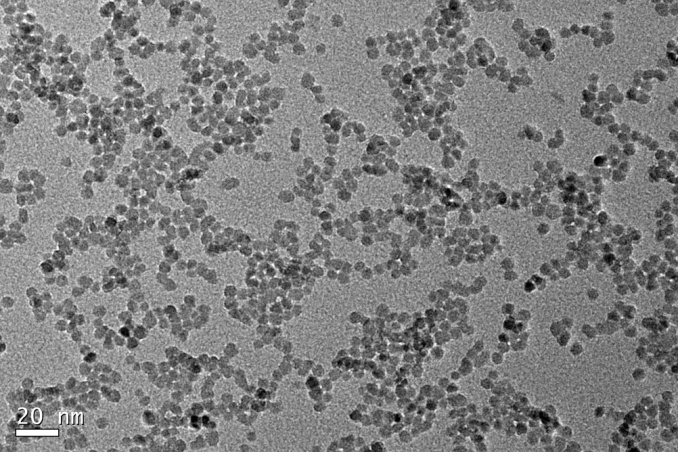
1641095766600895.png 1641095766600895.png

納米ZnO溶液
時間:2023-02-02 作者:
產品基本信息
| 產品名稱 Description | 納米ZnO溶液 Nano-ZnO solution |
| 產品編號 Product No | Z-Ink |
| 固體濃度 Solid Content | 0.95%-3.82% |
| 外觀顏色 Appearance | 無色透明 |
| 產品濃度范圍 | 10-40mg/mL |
| Mg 摻雜量 | -- |
| 顆粒尺寸 Particle Size | 4-7nm |
| 尺寸分布 | -- |
| 產品溶劑 Solvent | 乙醇 Ethanol |
| 粘度 | 1-3cP |
| 紫外吸收可變范圍 | 315-350nm |
| 保存條件 Storage | 4℃于干燥陰暗處保存 Stored at dry and ventilateplace at 4Celsius |
| 價格 | 歡迎來電垂詢 |
| 用途 | OLED、量子點電致發光器件、有機太陽能電池(OPV) |
| 吸收光譜 |
|
| TEM | ![]() |
| 產品圖片 | ![]() |
上一條:納米ZnMgO溶液